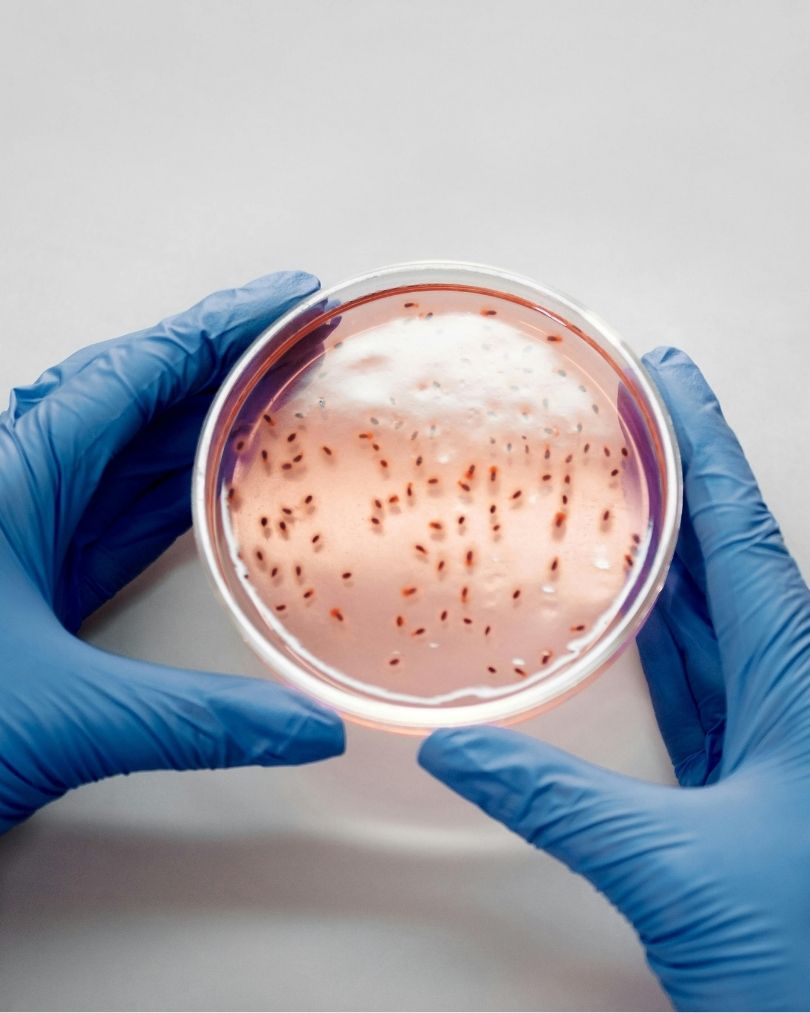

Di balik kenyamanan ruangan seperti rumah maupun kantor, udara di dalamnya ternyata bisa menjadi media penyebaran partikel tak kasat mata, termasuk bakteri yang berpotensi memengaruhi kesehatan.

Udara merupakan campuran banyak komponen yang terdiri dari gas, partikel padat, partikel cair, energi, ions, zat organik yang terdistribusi acak dan bebas mengikuti volume bentuk ruang. Udara dalam ruang (indoor air) merupakan udara di dalam gedung yang terperangkap sedikitnya satu jam yang dihuni oleh manusia dengan status kesehatan yang bervariasi. Ruangan tersebut bisa sebagai kantor, sekolah, fasilitas transportasi, pusat perbelanjaan, rumah sakit, dan rumah hunian. Kualitas udara dalam ruang merupakan masalah yang perlu mendapatkan perhatian karena akan berpengaruh terhadap kesehatan manusia. Pertumbuhan pembangunan seperti industri, transportasi, dan lain-lain disamping memberikan dampak positif namun disisi lain akan memberikan dampak negatif dimana salah satunya berupa pencemaran udara dan kebisingan baik yang terjadi di dalam ruangan (indoor) maupun di luar ruangan (outdoor) yang dapat membahayakan kesehatan manusia dan terjadinya penularan penyakit. Selain kualitas udara ambien, kualitas udara dalam ruangan (indoor air quality) juga merupakan masalah yang perlu mendapat perhatian karena akan berpengaruh terhadap kesehatan manusia dimana hampir 90 % hidup manusia berada dalam ruangan.
Sumber pencemaran udara dalam ruangan dirinci menjadi 5 sumber meliputi:
- Pencemaran akibat kegiatan penghuni dalam gedung seperti asap rokok, pestisida, bahan pembersih ruangan;
- Pencemaran dari luar gedung meliputi masuknya gas buangan kendaraan bermotor, cerobong asap dapur karena penempatan lokasi lubang ventilasi yang tidak tepat;
- Pencemaran dari bahan bangunan ruangan seperti formaldehid, lem, asbestos, fibreglass, dan bahan lainnya;
- Pencemaran mikroba meliputi bak teri, jamur, virus atau protozoa yang dapat ditemukan di saluran udara dan alat pendingin ruangan beserta seluruh sistemnya; dan
- Kurangnya udara segar yang masuk karena gangguan ventilasi udara dan kurangnya perawatan sistem peralatan ventilasi. Aktivitas di dalam gedung yang semakin banyak dapat meningkatkan jumlah polutan dalam ruangan. Kenyataan ini menyebabkan risiko terpaparnya polutan dalam ruangan terhadap manusia semakin tinggi
Udara yang tercemar dalam ruangan adalah salah satu penyebab utama penyakit dan kematian yang dapat dihindari. Udara pada dasarnya bukan tempat pertumbuhan dan reproduksi bakteri karena komposisi udara yang tidak sesuai. Di udara terbuka, kebanyakan bakteri berasal dari tanah. Bakteri pada udara kemungkinan terbawa oleh debu, uap air, angin dan penghuni ruangan. Bakteri di udara biasanya menempel pada permukaan tanah, lantai, ruangan, perabot ruangan maupun penghuni ruangan. Bakteri tersebut sebagian besar adalah saprofit dan bersifat non patogenik, tetapi dengan bertambahnya bakteri non patogenik dalam jumlah yang relatif besar dapat berpotensi sama seperti bakteri patogenik. Droplet dapat mempengaruhi jumlah bakteri pada udara. Bakteri disebarkan oleh droplet yang dikeluarkan melalui hidung atau mulut selama batuk, bersin, dan bicara. Droplet dalam ukuran kecil tetap tersuspensi di udara untuk periode waktu yang lama, sedangkan yang lebih besar jatuh dengan cepat sebagai debu. Selama ada aktivitas dalam ruangan, debu kembali melayang-layang sebagai akibat adanya gerakan udara. Kontak udara melalui aktifitas bernafas merupakan salah satu cara penyebaran penyakit terhadap pengguna ruangan.
Sumber pencemar udara dalam ruangan berupa fisik, kimia dan biologi. Pencemaran biologi dalam ruangan berupa mikroorganisme, polen, dan endospora. Keberadaan mikroorganisme dalam ruangan dipengaruhi oleh suhu, kelembaban, pencahayaan, kepadatan hunian dan sistem ventilasi. Suhu tinggi pada ruangan dapat menaikkan suhu air sehingga memudahkan proses penguapan air dan meningkatkan partikel air yang dapat memindahkan sel – sel kecil seperti debu yang berada di permukaan, sedangkan bakteri bisa terbawa oleh angin bersama debu. Kontaminasi bakteri dalam ruangan seringkali merupakan akibat dari terbentuknya kelembaban. Bila kelembaban ruangan di atas 60% akan menyebabkan berkembangnya organisme patogen maupun organisme yang bersifat allergen.
Faktor yang Mempengaruhi Pertumbuhan Bakteri
Bakteri membutuhkan nutrien untuk kehidupan dan pertumbuhannya. Nutrien dibutuhkan bakteri sebagai sumber karbon, sumber nitrogen, sumber energi dan faktor pertumbuhan. Ketiadaan atau kekurangan sumber-sumber nutrisi ini dapat mempengaruhi pertumbuhan bakteri hingga pada akhirnya dapat menyebabkan kematian.
Kondisi tidak bersih dan higienis pada lingkungan adalah kondisi yang menyediakan sumber nutrisi bagi pertumbuhan mikroba sehingga mikroba dapat tumbuh berkembang di lingkungan seperti ini.
Media pertumbuhan bakteri dapat ditambahkan beberapa nutrisi faktor pertumbuhan yang disesuaikan dengan kebutuhan bakteri. Media nutrient agar merupakan media berbentuk padat yang mengandung sumber nitrogen untuk perhitungan bakteri.
Setiap bakteri mempunyai suhu optimum. Pada suhu optimum ini, pertumbuhan bakteri berlangsung dengan cepat. Suhu mempengaruhi pembelahan sel bakteri pada suhu yang tidak sesuai dengan kebutuhan bakteri dapat menyebabkan kerusakan sel. Suhu lingkungan yang lebih tinggi dari suhu yang dibutuhkan bakteri akan menyebabkan denaturasi protein dan komponen sel esensial lainnya sehingga sel akan mati. Demikian pula bila suhu lingkungannya berada di bawah batas toleransi, membran sitoplasma tidak akan berwujud cair sehingga transportasi nutrisi akan terhambat dan proses kehidupan sel akan terhenti. Alat yang digunakan untuk mengukur suhu ruang yaitu termometer. Termometer suhu ruang merupakan salah satu thermometer yang cukup peka. Thermometer suhu ruang berskala -50°C sampai dengan +50°C. Konsentrasi oksigen yang tersedia mempengaruhi jenis dan pertumbuhan bakteri. Oksigen dibutuhkan bakteri untuk proses respirasi (untuk merubah makanannya menjadi energi).
Cahaya juga dapat mempengaruhi pertumbuhan bakteri. Adanya sumber cahaya dalam ruangan dapat menghambat pertumbuhan bakteri. Pencahayaan harus cukup baik waktu siang maupun malam hari. Pada malam hari pencahayaan yang ideal adalah penerangan listrik sedangkan pada waktu pagi hari sinar matahari dapat menjadi sumber utama penerangan dalam ruangan. Umumnya pertumbuhan bakteri juga membutuhkan kelembaban yang tinggi, kelembaban yang dibutuhkan di atas 85 %. Sumber kelembaban dalam ruangan berasal dari konstruksi bangunan yang tidak baik seperti atap yang bocor, lantai, dan dinding rumah yang tidak kedap air, serta kurangnya pencahayaan baik buatan maupun alami. Kelembaban relatif udara yang tinggi dapat meningkatkan pertumbuhan mikroorganisme. Pengurangan kadar air atau kelembaban dari protoplasma menyebabkan kegiatan metabolism terhenti. Alat untuk mengukur kelembaban ruangan yaitu menggunakan hygrometer.
Penghuni dalam ruangan juga berpengaruh terhadap suhu, dan penyebaran bakteri dalam ruangan. Jumlah penghuni dalam ruangan mempengaruhi suhu dalam ruangan. Semakin banyak penghuni maka udara akan menjadi semakin panas. Selain itu bakteri juga bisa terbawa oleh panghuni dan menyebar ke udara sekitar ruangan sehingga mengkontaminasi udara ruangan. Penghuni dalam ruangan dapat juga berasal dari penghuni itu sendiri berasal dari droplet yang di keluarkan melalui batuk, bersin dan berbicara. Menghitung kepadatan hunian ruangan dapat dilihat dari luas ruangan, jumlah penghuni dalam ruangan dengan rumus sebagai berikut :

Dampak langsung pencemaran udara dalam ruangan terhadap tubuh yang kontak langsung dengan udara tercemar bakteri sebagai berikut:
- Iritasi selaput lendir :iritasi mata, mata pedih, mata merah serta berair.
- Iritasi hidung : bersin dan gatal pada area hidung.
- Iritasi tenggorokan : sakit menelan, gatal dan batuk kering.
- Gangguan neurotoksik : sakit kepala, lemah, capek, mudah tersinggung, sulit berkonsentrasi.
- Gangguan paru dan pernafasan : batuk, nafas berbunyi, sesak nafas, rasa berat di dada.
- Gangguan kulit : kulit kering dan gatal.
- Gangguan saluran cerna : diare.
- Gangguan lainnya seperti gangguan perilaku, gangguan saluran kencing, sulit belajar.
Dampak lain yang ditimbulkan dari pencemaran udara antara lain beberapa gangguan kesehatan akibat bakteri patogen di udara antara lain dapat menimbulkan berbagai macam penyakit seperti alergi, asma serta kanker. Penyakit yang ditimbulkan secara tidak langsung tetapi akan diakumulasikan sedikit demi Sedikit dan membebani tubuh sehingga menyebabkan penyakit kronis. Selain dampak tersebut, terdapat pula penyakit yang disebarkan melalui udara.Penyakit yang disebarkan melalui media udara berasal dari aktivitas manusia seperti batuk, bersih atau meludah atau sering disebut dengan droplet. Droplet berperan sebagai sumber bakteri patogen di udara. Droplet adalah partikel air kecil (seperti hujan rintik-rintik) dengan ukuran sekitar 1-5 micrometer. Karena ukurannya yang sangat kecil, bentuk ini dapat tetap berada di udara untuk waktu yang cukup lama dan dapat diisap pada waktu bernafas dan masuk ke alat pernafasan. Tetesan cairan (aerosol) biasanya dibentuk oleh bersin, batuk dan berbicara.
Perkembangan Bakteri Pada Ruangan AC (Air Conditioner)
Beberapa penyakit paru disebabkan oleh mikroorganisme yang mengkontaminasi udara dan berkembang biak di dalam AC. Mikroorganisme hidup pada pipa AC yang menyalurkan udara dingin ke ruangan. Penggunaan AC yang mewajibkan tertutupnya seisi ruang dapat mengakibatkan pertumbuhan kuman, bakteri, dan virus penyebab penyakit semakin subur. Bakteri tumbuh pada tempat yang lembab. Udara yang dihasilkan oleh AC berdapak turunnya temperatur suhu ruangan sehingga ruangan menjadi lembab. Bila suhu terlalu rendah dan kelembaban meningkat yang pastinya jamur dan parasit akan timbul. Tempat atau rumah dan AC yang tidak di jaga kebersihannya juga penyebab utama masalah kesehatan. Sistem kerja AC adalah menyerap udara panas kemudian diubah menjadi dingin. Apabila udara panas yang terserap adalah dari tempat yang kotor maka udara dingin yang dihasilkan AC akan kotor. Filter dalam unit penyejuk udara / AC dirancang untuk mencegah penyebaran bakteri dan virus. Namun, dalam tugasnya filter AC mengumpulkan polutan. Dalam proses itu bakteri dapat berkembang biak pada filter AC jika tidak dibersihkan secara teratur dan menyebarkan bakteri ke udara.
SG8 Group
Sutanto Group (SG8) adalah perusahaan induk yang telah didirikan sejak tahun 1989 dan mencakup PT Citra Mandiri Cemerlang Prima serta PT Dwitunggal Jaya Pratama Maju sebagai anak perusahaannya.
Selama 35 tahun, kami telah membantu banyak klien dari baik perusahaan lokal maupun multinasional. SG8 Group adalah merek baru kami untuk perusahaan induk, yang juga memiliki layanan:

- Manpower Supply
- Facility & Cleaning Services
- Company & Personal Vehicle Rental
- Business Consulting & Strategy Development
- Messenger Service Document Export-Import
- Branding Activation
Dengan cakupan layanan yang luas dan pengalaman yang terus berkembang, SG8 Group hadir sebagai mitra yang memahami dinamika bisnis di berbagai industri. Kami percaya bahwa setiap kebutuhan operasional memerlukan pendekatan yang tepat dan dapat diandalkan.
Jika Anda sedang mencari Solusi yang mampu mendukung keberlanjutan dan pertumbuhan bisnis Anda, SG8 Group siap menjadi bagian dari perjalanan tersebut.
Kami terbuka untuk diskusi awal atau konsultasi tanpa biaya agar kami dapat memahami kebutuhan spesifik perusahaan Anda dan menawarkan solusi yang paling sesuai.
Untuk informasi lebih lanjut dan atau untuk mengatur waktu diskusi hubungi kami di:
Our Clients
Logistics and Freight Forwarding



Manufacturing and Industry






Automotive and Transportations


Tourism and Travel




Banking and Finance




Food And Beverage (F & B)



Property and Real Estate







Hospital And Health

Education



Our Clients
Logistics and Freight Forwarding

Manufacturing and Industry


Automotive and Transportations

Tourism and Travel


Banking and Finance

Food And Beverage (F & B)

Property and Real Estate



Hospital And Health

Education














